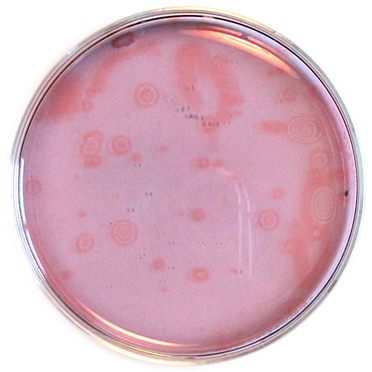
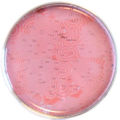
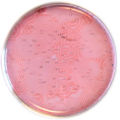
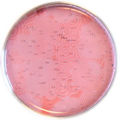

Réaction oscillante de Belousov-Zhabotinsky
Il s'agit de la fameuse expérience, réalisée par Belousov et dont l'explication a été donnée plus tard par Zhabotinsky, d'une réaction oscillante dans le temps et dans l'espace, visible grâce à deux couleurs : bleu et rouge.
Il existe de nombreuses variations de cette expérience, certaines à base de cérium (nitrate de cérium (IV) ammoniacal ![]()
![]() ), ou des réactions oscillantes similaires à base de manganèse. L'expérience présentée ici est la plus simple de toutes et donne un bon résultat à chaque fois (même en étant approximatif sur les masses et volumes mesurés, l'expérience fonctionne bien).
), ou des réactions oscillantes similaires à base de manganèse. L'expérience présentée ici est la plus simple de toutes et donne un bon résultat à chaque fois (même en étant approximatif sur les masses et volumes mesurés, l'expérience fonctionne bien).
Sommaire
1 Précautions
Outre les précautions en chimie qui sont d'usage, cette expérience comporte les attentions suivantes :
- En raison de l'acidité des solutions
 et du risque cancérogène
et du risque cancérogène  et nocif
et nocif  de certains réactifs, il faudra porter blouse, gants et lunettes de protection.
de certains réactifs, il faudra porter blouse, gants et lunettes de protection. - D'autre part il se dégage en début d'expérience des vapeurs de dibrome


 toxiques et corrosives pour les yeux, les voies respiratoires et la peau. Il faudra donc travailler sous une hotte aspirante ou dans un endroit bien aéré.
toxiques et corrosives pour les yeux, les voies respiratoires et la peau. Il faudra donc travailler sous une hotte aspirante ou dans un endroit bien aéré.
2 Matériel et produits
- Bromate de sodium NaBrO3



- Acide sulfurique H2SO4
 (la solution commercialisée pour les batteries au plomb est suffisante)
(la solution commercialisée pour les batteries au plomb est suffisante) - Acide malonique

- Bromure de sodium NaBr
- Solution de ferroïne (généralement vendue à 0,025 mol/L)
- Eau distillée
- 2 fioles jaugées de 50 mL
- 1 boîte de Petri
3 Protocole
3.1 Préparation des solutions
- Solution A : dans une fiole jaugée de 50 mL, introduire
- 3,8 g de bromate de sodium NaBrO3



- 10 mL d'acide sulfurique H2SO4

- de l'eau distillée jusqu'au trait de jauge, après homogénéisation de la solution.
- 3,8 g de bromate de sodium NaBrO3
- Solution B : dans une fiole jaugée de 50 mL, introduire
- 3,6 g d'acide malonique

- 1,7 g de bromure de sodium NaBr
- de l'eau distillée jusqu'au trait de jauge, après homogénéisation de la solution.
- 3,6 g d'acide malonique
3.2 Réaction oscillante
- Sous une hotte aspirante ou dans une pièce ventilée, verser dans un bécher 40 mL de solution A et 10 mL de solution B.
- Une couleur brune apparaît suivie de vapeurs rousses irritantes de dibrome Br2


 .
. - Agiter avec une spatule jusqu'à ce que la solution devienne jaune très pâle ou incolore (cela prend environ une minute).
- Ajouter alors 1 mL de solution de ferroïne et continuer l'agitation. Pour des couleurs bien marquées, on peut ajouter encore plus de ferroïne.
- Après quelques secondes, la couleur passe immédiatement du rouge au bleu, pendant une seconde au maximum, puis un retour vers le rouge en passant par le violet (mélange de bleu et rouge). Il s'ensuit des oscillations temporelles entre le rouge et le bleu, dont la période est de l'ordre de 30 secondes (variable selon la température ambiante).
- Une fois que ceci a été bien observé dans le bécher, transférer le mélange dans un tube à essai. On remarque parfois que le changement de coloration se fait à un bout du tube et se propage rapidement à la totalité du tube. Observer ceci pendant quelques minutes.
- Une fois que ceci a été bien observé dans le tube, verser le mélange dans une boîte de Petri bien horizontale de sorte que le liquide ait une épaisseur inférieure à 1 mm. Laisser les oscillations continuer et observer la formation de taches desquelles partent des ondes chimiques dont les couleurs alternent. Observer la propagation de ces ondes dans la boîte de Petri et les interactions entre ondes. Il est possible à chaque fois de bien mélanger la solution pour revenir à une solution homogène sans taches. Il est possible aussi, à l'aide de la spatule, de perturber les taches pour obtenir des formes alongées. En posant la boîte de Petri sur un rétroprojecteur il est possible de monter ceci sur un grand écran.
- La réaction durera quelques minutes, après quoi la couleur restera homogène.
4 Explications
Pour expliquer le phénomène de réaction cyclique, on utilise souvent un modèle simple de renards-lapins-herbe : on imagine une pairie de surface finie contenant de l'herbe, des lapins et des renards. Les règles de base sont :
- Les lapins mangent de l'herbe. Ainsi, ils peuvent se nourrir et se reproduire. Cela augmente leur population.
- Les renards mangent les lapins. Ainsi, ils peuvent se nourrir et se reproduire. Cela augmente leur population.
- La quantité d'herbe est limitée.
On peut alors étudier l'évolution de quelques situations limites, en représentant dans un graphique l'évolution des populations de lapins et de renards par un point figuratif repérant le nombre d'animaux :
- S'il n'y a que des lapins et aucun renard (1), les lapins se nourrissent et se reproduisent. Comme il n'y a aucun prédateur (renards), la population de lapins va augmenter (2). Cependant, lorsqu'ils auront consommé toute l'herbe disponible, ils mourront tous ! (3)
- S'il n'y a que des renards et aucun lapin (1), les renards vont mourir de faim (ils ne sont pas herbivores) et leur population va tendre vers zéro (2).
- Dans le cas où il y a une grand quantité de renards et peu de lapins (1), la quantité de lapin diminue rapidement car mangés par les renards, lesquels à leur tour meurent de faim (2).
- Mais on peut imaginer une situation qui n'aboutira pas à la mort totale des espèces, dans laquelle il y a beaucoup de lapins et des renards (1). Ainsi les renards peuvent manger les lapins et se reproduire : la population de lapin diminue et celle des renards augmente (2). De fait il y a tellement de renards qu'ils mangent des lapins plus vite. La population de lapin continue à diminuer, et par conséquent la population de renards aussi, ayant moins à manger (3). Cependant, si la quantité de renards diminue, les lapins sont plus tranquilles pour se reproduire et augmenter leur nombre (4). Mais alors la quantité de lapins augmentant, les renards restant peuvent se nourrir mieux de nouveau et se reproduire, on retrouve la situation (1).
- Bien sûr, un tel cycle ne se répétera pas exactement de la même manière à chaque tour, en raison des fluctuations aléatoires que subissent les populations de renards et lapins. Et bien sûr, ce cycle ne pourra se faire indéfiniment car la véritable variable limitante du système est l'herbe : quand les lapins auront consommé toute l'herbe, les lapins mourront, suivis par les renards ! Le système tendra inévitablement vers cet état d'équilibre. Cette variable "cachée" de l'herbe n'apparaît pas dans la représentation en 2 dimensions, mais on peut faire une représentation en 3 dimensions :
Pour expliquer la réaction cyclique de Belouzov-Zhabotinsky, on peut donc (en première approximation et simplement) remplacer l'herbe, les lapins et les renards par les noms des 3 molécules qui réagissent ensemble, selon des réactions concurrentes et simultanée dans le mélange. Supposons que la "molécule lapin" soit rouge et la "molécule renard" soit bleue, alors on verra affectivement la couleur passer cycliquement du rouge au bleu, puis au violet, puis au rouge... ainsi de suite, et jusqu'à épuisement du réactif qui n'est pas forcément visible mais qui limite l'ensemble du processus chimique.
5 Illustration
Après quelques minutes, de belles structures (cliquer pour agrandir) :
6 En savoir plus
Pour une autre expérience, plus simple, mettant en jeu deux réactions chimiques simultanées avec des cinétiques différentes, consulter : Réaction chronomètre à l'iode
7 Vidéo
- Expérience de Belousov-Zhabotinsky (9,2 Mo, format QuickTime)